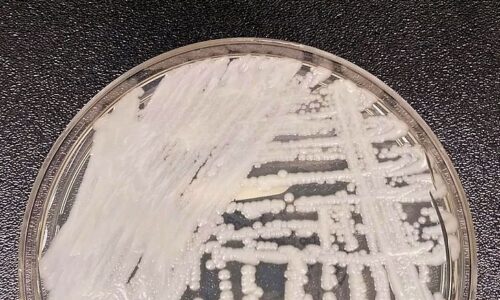

Anvisa recomenda a suspensão definitiva de cruzeiros no Brasil
A Anvisa (Agência Nacional de Vigilância Sanitária) recomendou a suspensão definitiva da temporada de navios de cruzeiro no Brasil, como ação necessária à proteção da saúde...
Campo Grande: Passagem de ônibus sobe para R$ 4,40 na próxima segunda-feira
O preço da passagem do transporte coletivo em Campo Grande vai subir de R$ 4,20 para R$ 4,40, na próxima segunda-feira (17). O reajuste para linha como convencional...
Aplicação de vacina 100% brasileira deve começar em fevereiro
O Ministério da Saúde informou nesta quarta-feria (12) que as primeiras doses da vacina contra Covid-19 100% nacional começarão a ser aplicadas na primeira semana de fevereiro....
Prefeito Juvenal valoriza profissional do município e apresenta novo Secretário de Saúde
Nesta quarta-feira (12) o prefeito de Figueirão Juvenal Consolaro apresentou para os funcionários do hospital e das UBS o novo secretário de saúde Pedro Alexandre...
Seca em MS: Ministra Tereza Cristina visita Regiões no Estado
Nesta quinta-feira (13), a Ministra da Agricultura, Pecuária e Abastecimento do Brasil (Mapa) Tereza Cristina, visitará regiões atingidas pela seca em Mato Grosso do Sul....
Misteriosos crânios alienígenas encontrados na África poderão mudar a história humana!
Embora muitas pessoas pensem que nós somos a única forma de vida inteligente que sempre habitou esse planeta com essa descoberta essas alegações podem estar...
Anvisa confirma novo caso do superfungo Candida auris
A Agência Nacional de Vigilância Sanitária (Anvisa) informou que foi notificada sobre a terceira infecção pelo fungo Candida auris. O caso foi diagnosticado em um hospital...